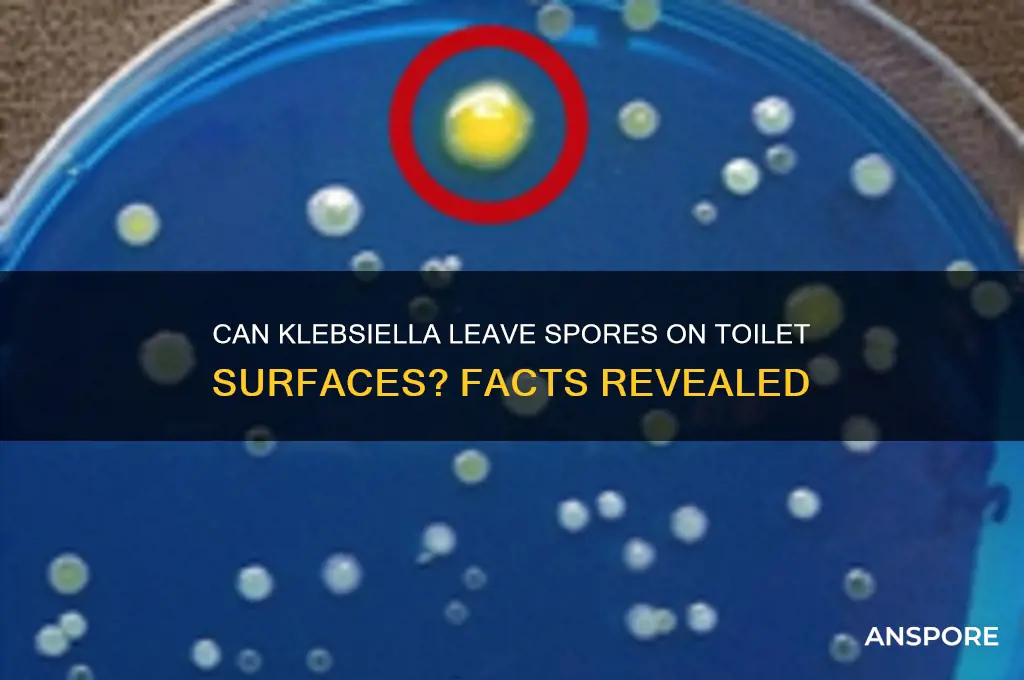
can klebsiella leave spores on toilet

Klebsiella, a genus of Gram-negative bacteria commonly found in the human gut, is known for its ability to cause infections, particularly in healthcare settings. While Klebsiella does not form spores like some other bacteria (e.g., Clostridium difficile), it can survive on surfaces, including toilets, for extended periods. This resilience raises concerns about its potential to contaminate bathroom environments and contribute to the spread of infections. Understanding whether Klebsiella can leave viable cells or biofilms on toilets is crucial for implementing effective hygiene practices and preventing transmission, especially in hospitals and public spaces.
| Characteristics | Values |
|---|---|
| Sporulation Ability | Klebsiella species are non-spore-forming bacteria. They do not produce spores under any conditions, including on surfaces like toilets. |
| Survival on Surfaces | Klebsiella can survive on surfaces like toilets for hours to days, depending on environmental factors (e.g., moisture, temperature). |
| Transmission | Spread primarily via fecal-oral route or contact with contaminated surfaces, not through spores. |
| Disinfection | Standard disinfectants (e.g., bleach, alcohol) are effective against Klebsiella on surfaces, as it does not form spores. |
| Clinical Relevance | Klebsiella is a common cause of healthcare-associated infections (e.g., urinary tract infections, pneumonia), but not due to spore persistence. |
| Environmental Persistence | Survives better in moist environments, but does not form spores for long-term survival. |
| Risk on Toilets | Contamination is possible, but spores are not a concern since Klebsiella does not produce them. |
Explore related products
What You'll Learn

Klebsiella spore formation conditions
Klebsiella, a genus of Gram-negative bacteria, is primarily known for its ability to cause opportunistic infections, particularly in healthcare settings. Unlike spore-forming bacteria such as *Clostridium difficile*, Klebsiella species do not naturally produce spores under typical environmental conditions. Spores are highly resistant structures that allow some bacteria to survive extreme conditions, but Klebsiella relies on other mechanisms, like biofilm formation, to persist in hostile environments. This raises the question: under what conditions might Klebsiella theoretically form spores, and could such conditions exist on a toilet?
To explore this, it’s essential to understand the biological requirements for spore formation. Sporulation in bacteria like *Bacillus* and *Clostridium* is triggered by nutrient deprivation, desiccation, or other environmental stresses. Klebsiella, however, lacks the genetic machinery for sporulation, making it highly unlikely to form spores even under extreme stress. While some studies have explored genetic engineering to induce spore-like structures in non-spore-forming bacteria, these are laboratory manipulations, not natural occurrences. Thus, the idea of Klebsiella leaving spores on a toilet is biologically implausible.
Even if we hypothetically consider conditions on a toilet—such as exposure to cleaning agents, temperature fluctuations, or moisture—these would not trigger spore formation in Klebsiella. Instead, such conditions might reduce its viability or promote biofilm growth, which can protect the bacteria from disinfection. For instance, toilets in healthcare settings may harbor Klebsiella in biofilms, but these are vegetative cells, not spores. Proper cleaning with disinfectants like bleach (5% sodium hypochlorite solution) or quaternary ammonium compounds can effectively eliminate these cells, reducing infection risks.
From a practical standpoint, the focus should be on preventing Klebsiella contamination rather than worrying about non-existent spores. Regular disinfection of toilets, especially in healthcare environments, is critical. Use of disposable toilet brushes, frequent hand hygiene, and avoiding touching surfaces after flushing can minimize transmission. For immunocompromised individuals or those in high-risk settings, additional precautions like using toilet seat covers or sanitizing wipes may be advisable. Understanding Klebsiella’s true survival mechanisms—not hypothetical spore formation—is key to effective infection control.
Can Flood Spores Wait? Understanding Their Survival and Dormancy Mechanisms
You may want to see also

Toilet surfaces and spore survival
Klebsiella, a genus of Gram-negative bacteria, is known for its ability to cause infections, particularly in healthcare settings. While Klebsiella does not form spores, its survival on toilet surfaces raises concerns about cross-contamination. Toilet surfaces, including seats, handles, and flush mechanisms, are frequently touched and can harbor bacteria for extended periods. Studies show that Gram-negative bacteria like Klebsiella can survive on dry surfaces for up to 48 hours, depending on environmental conditions such as humidity and temperature. This highlights the importance of regular disinfection to minimize the risk of transmission.
To effectively reduce bacterial survival on toilet surfaces, follow a two-step cleaning process. First, clean the surface with soap or detergent to remove organic matter, as this enhances the efficacy of disinfectants. Second, apply a disinfectant with proven efficacy against Gram-negative bacteria, such as a 1:10 bleach solution or an EPA-registered product. Allow the disinfectant to remain on the surface for the manufacturer-recommended contact time, typically 3–5 minutes. For high-touch areas in shared spaces, increase cleaning frequency to at least twice daily, especially in healthcare or public facilities.
Comparing toilet surfaces, stainless steel and plastic—common materials in toilets—differ in bacterial retention. Stainless steel tends to retain bacteria for shorter periods than plastic due to its non-porous nature. However, both materials require thorough cleaning and disinfection. In contrast, porous surfaces like unglazed ceramic tiles are more challenging to sanitize and should be avoided in high-risk areas. When selecting toilet fixtures, prioritize materials that are easy to clean and resistant to bacterial adhesion.
A practical tip for individuals is to use disposable toilet seat covers or wipes in public restrooms, reducing direct contact with potentially contaminated surfaces. For home use, install hands-free flushing systems and use antimicrobial coatings on high-touch areas. Educate household members or staff on proper hand hygiene, as hands are the primary vector for bacterial transfer. By combining surface disinfection with behavioral practices, the risk of Klebsiella and other pathogens spreading via toilet surfaces can be significantly mitigated.
Are All Spores Diploid? Unraveling the Genetic Makeup of Spores
You may want to see also

Risk of spore transmission
Klebsiella, a genus of Gram-negative bacteria, is primarily known for causing healthcare-associated infections, particularly in immunocompromised individuals. While Klebsiella species are not typically spore-forming, their ability to persist in environments like toilets raises concerns about transmission. Unlike spore-forming bacteria such as Clostridioides difficile, Klebsiella relies on biofilm formation to survive on surfaces. However, the risk of transmission from toilet surfaces remains significant due to its resilience in moist environments and its ability to colonize the gastrointestinal tract. Understanding this risk is crucial for implementing effective hygiene practices in both healthcare and household settings.
Analyzing the transmission dynamics, Klebsiella can survive on toilet surfaces for extended periods, especially in the presence of organic matter or residual moisture. Studies have shown that Klebsiella pneumoniae, a common pathogen, can persist on plastic and ceramic surfaces for up to 30 days. This longevity increases the likelihood of indirect transmission, particularly in shared restrooms. For instance, improper hand hygiene after using a contaminated toilet can transfer the bacteria to hands, which then act as vectors to other surfaces or individuals. High-risk groups, such as the elderly, infants, and those with chronic illnesses, are more susceptible to infection, making this a critical concern in care facilities.
To mitigate the risk of Klebsiella transmission from toilets, specific preventive measures are essential. Regular disinfection of toilet surfaces using EPA-approved disinfectants with active ingredients like chlorine bleach or quaternary ammonium compounds is highly effective. These agents can reduce bacterial load by 99.9% within 10 minutes of contact. Additionally, installing hands-free flushing mechanisms and touchless faucets can minimize surface contact. For households, ensuring proper ventilation in bathrooms and using disposable toilet brushes can further reduce bacterial persistence. Educating individuals on the importance of thorough handwashing with soap for at least 20 seconds is equally vital.
Comparatively, while spore-forming bacteria pose a higher risk due to their ability to withstand harsh conditions, Klebsiella’s environmental persistence should not be underestimated. Unlike spores, Klebsiella is more susceptible to desiccation, but its ability to form biofilms compensates for this vulnerability. In healthcare settings, where Klebsiella infections are more prevalent, stringent protocols such as daily disinfection of high-touch surfaces and the use of personal protective equipment (PPE) are non-negotiable. Households, however, often lack such rigorous practices, making them potential reservoirs for transmission. Bridging this gap through public awareness campaigns could significantly reduce community-acquired infections.
In conclusion, while Klebsiella does not leave spores on toilets, its ability to survive and form biofilms on these surfaces poses a tangible transmission risk. By adopting targeted hygiene practices, such as regular disinfection and improved hand hygiene, individuals can effectively minimize this risk. Healthcare facilities must maintain stringent protocols, while households should emulate these practices to protect vulnerable populations. Awareness and action are key to preventing Klebsiella transmission in everyday environments.
Effective Mold Removal: Cleaning Clothes Exposed to Mold Spores
You may want to see also
Explore related products

Cleaning methods to remove spores
Klebsiella, a genus of bacteria known for its resilience, can indeed leave spores on surfaces, including toilets. While not all Klebsiella species form spores, those that do pose a challenge due to their ability to survive harsh conditions. Spores are highly resistant structures that can withstand desiccation, heat, and many disinfectants, making their removal critical in maintaining hygiene.
Analytical Perspective:
The effectiveness of cleaning methods hinges on their ability to disrupt spore structure or denature their proteins. Traditional household cleaners often fail against spores due to their low concentration of active ingredients. For instance, bleach (sodium hypochlorite) is commonly used but requires a 1:10 dilution (1 part bleach to 10 parts water) and a 10-minute contact time to be effective. However, spores may still persist if the surface is not thoroughly wetted or if organic matter (like urine or feces) shields them. Studies show that spores exposed to 70% isopropyl alcohol for 30 minutes are inactivated, but this method is impractical for toilet surfaces due to evaporation risks.
Instructive Approach:
To remove Klebsiella spores from toilets, follow a two-step process. First, clean the surface with a detergent-based cleaner to remove organic debris, ensuring no visible soiling remains. Second, disinfect using a spore-specific agent like a 10% bleach solution or a commercial sporicide (e.g., those containing hydrogen peroxide or peracetic acid). Apply the disinfectant liberally, allow it to sit for the manufacturer’s recommended time (typically 10–20 minutes), and scrub thoroughly to dislodge any remaining spores. For high-risk environments, such as healthcare settings, steam cleaning at 121°C (250°F) for 30 minutes is highly effective but impractical for home use.
Comparative Analysis:
While bleach is widely available, it corrodes surfaces over time and poses inhalation risks. Alternatively, hydrogen peroxide-based disinfectants (3–7% concentration) are safer and equally effective against spores, with the added benefit of decomposing into water and oxygen. Steam cleaning, though resource-intensive, offers a chemical-free solution but requires specialized equipment. For households, a combination of mechanical action (scrubbing) and a peroxide-based disinfectant strikes a balance between efficacy and practicality.
Descriptive Insight:
Imagine a toilet bowl with microscopic spores clinging to its surface, shielded by a biofilm of organic matter. A thorough cleaning regimen begins with a stiff-bristled brush to disrupt this biofilm, followed by a foaming disinfectant that clings to vertical surfaces longer than liquid solutions. After rinsing, the once-contaminated surface is now free of visible and microscopic threats, ensuring a safer environment. Regular maintenance, such as daily cleaning with a disinfectant wipe and weekly deep cleaning, prevents spore accumulation and reduces the risk of infection.
Persuasive Argument:
Ignoring spore removal from toilets is not just a matter of aesthetics but of public health. Klebsiella infections, particularly from antibiotic-resistant strains like Klebsiella pneumoniae carbapenemase (KPC), can be life-threatening. By adopting rigorous cleaning protocols, individuals protect not only themselves but also vulnerable populations, such as the elderly or immunocompromised. Investing in the right tools and products is a small price to pay for peace of mind and community safety.
Teaching Breloom Spore: Strategies and Tips for Effective Training
You may want to see also

Health risks from toilet spores
Klebsiella, a genus of bacteria commonly found in the human gut, can indeed leave traces on toilet surfaces, raising concerns about potential health risks. These bacteria are opportunistic pathogens, meaning they can cause infections, particularly in individuals with weakened immune systems. While Klebsiella does not form spores like some other bacteria (e.g., Clostridioides difficile), it can survive on surfaces for extended periods, increasing the likelihood of transmission. This persistence highlights the importance of understanding the health risks associated with toilet-borne bacteria and implementing effective hygiene practices.
One of the primary health risks from toilet spores or bacteria like Klebsiella is the potential for urinary tract infections (UTIs). These infections often occur when bacteria from the perianal area are transferred to the urethra, a process that can be facilitated by poor hygiene or contaminated surfaces. For example, touching a toilet seat or handle harboring Klebsiella and then failing to wash hands properly can introduce the bacteria to the urinary tract. Studies show that UTIs are more common in women, older adults, and individuals with catheter use, making these groups particularly vulnerable. To mitigate this risk, it is crucial to wipe front to back after using the toilet, wash hands thoroughly with soap and water for at least 20 seconds, and disinfect high-touch surfaces regularly.
Another significant concern is the role of Klebsiella in healthcare-associated infections (HAIs). In hospital settings, Klebsiella can colonize toilets and other surfaces, posing a threat to patients with compromised immune systems. For instance, Klebsiella pneumoniae, a common species within the genus, is a leading cause of hospital-acquired pneumonia and bloodstream infections. These infections can be life-threatening, with mortality rates ranging from 20% to 50% in severe cases. To prevent the spread of Klebsiella in healthcare environments, strict infection control measures are essential, including the use of disinfectants effective against Gram-negative bacteria and adherence to hand hygiene protocols.
Comparatively, while Klebsiella does not form spores, its ability to survive in dry conditions for days to weeks makes it a formidable pathogen. Unlike spore-forming bacteria, which can remain dormant for years, Klebsiella relies on its resilience and ability to form biofilms on surfaces. This distinction underscores the need for regular cleaning rather than sporadic deep cleaning. Households can reduce the risk of Klebsiella transmission by using EPA-approved disinfectants, ensuring proper ventilation in bathrooms, and replacing worn-out toilet brushes, which can harbor bacteria.
In conclusion, while Klebsiella does not leave spores on toilets, its persistence on surfaces poses tangible health risks, particularly for vulnerable populations. By understanding the mechanisms of transmission and implementing targeted hygiene practices, individuals can significantly reduce the likelihood of infections. Whether in a home or healthcare setting, proactive measures such as handwashing, surface disinfection, and proper bathroom etiquette are essential in combating the spread of Klebsiella and other toilet-borne pathogens.
Can Acidic Solutions Effectively Kill Botulinum Spores? Exploring the Science
You may want to see also
Frequently asked questions
No, Klebsiella does not form spores. It is a non-spore-forming bacterium, so it cannot leave spores on surfaces like toilets.
Klebsiella can survive on surfaces like toilets for several hours to days, depending on environmental conditions such as humidity and temperature.
Yes, touching a contaminated toilet and then touching your mouth, nose, or eyes can potentially lead to infection, especially if you have a weakened immune system.
Regularly clean and disinfect the toilet using household disinfectants or bleach solutions, and practice good hand hygiene to reduce the risk of transmission.






























